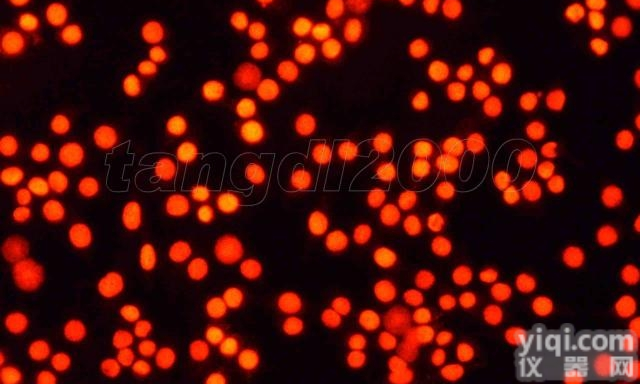
JRD240  免疫荧光（<em>细胞</em>）<em>实验</em><em>外包</em>

细胞实验外包
 北京吉田生物科技有限位于生命科学园北大YL产业园,公司主营业务是针对医学 研究人员的实验技术外包服务,提供课题设计和实施的整体解决方案,致力于 提高医学研究的效率和成功率。我们的管理和研发队伍主要由北京高校和医院的应届博士和博士后组成,确保实验技术水平处于国内领先水平。我们的技术服务以动物实验为核心,团队成员具有动物生理学博士教育背景,熟悉动物实验,综合运用分子生物学技术,帮助您解答与人类健康息息相关的生理学问题。动物实验提供实验小鼠托管、小鼠疾病模型制备、转基因小鼠模型建立和转基因小鼠表型分析等服务,利用专业的动物实验技能,协助医生GX的解决临床科研问题。技术服务常规的分子生物学技术实验,如DNA和RNA分子检测实验、蛋白质的定量和定位实验、细胞培养与信号通路研究以及英文论文作图和编辑服务。特色产品一站式试剂订购服务,根据用户的实验目的,有针对性的推荐商品化试剂,省去用户筛选的精力和时间,我们优化采购流程和供应商,保证价格与质量,并提供技术支持。
北京吉田生物科技有限位于生命科学园北大YL产业园,公司主营业务是针对医学 研究人员的实验技术外包服务,提供课题设计和实施的整体解决方案,致力于 提高医学研究的效率和成功率。我们的管理和研发队伍主要由北京高校和医院的应届博士和博士后组成,确保实验技术水平处于国内领先水平。我们的技术服务以动物实验为核心,团队成员具有动物生理学博士教育背景,熟悉动物实验,综合运用分子生物学技术,帮助您解答与人类健康息息相关的生理学问题。动物实验提供实验小鼠托管、小鼠疾病模型制备、转基因小鼠模型建立和转基因小鼠表型分析等服务,利用专业的动物实验技能,协助医生GX的解决临床科研问题。技术服务常规的分子生物学技术实验,如DNA和RNA分子检测实验、蛋白质的定量和定位实验、细胞培养与信号通路研究以及英文论文作图和编辑服务。特色产品一站式试剂订购服务,根据用户的实验目的,有针对性的推荐商品化试剂,省去用户筛选的精力和时间,我们优化采购流程和供应商,保证价格与质量,并提供技术支持。1 客户需提供自己感兴趣的研究领域、项目名称方向、前期研究结果、申请遭拒的课题实验标书及评审意见书,以及拟申请项目的空白模板。
2、生物外包设计:提供需要研究从事方向,课题基础,实验室条件,预算课题经费,导师相关要求。
3、课题整体服务:客户须提供详细相关资料,包括实验条件,实验经费预算,科研基础,隶属单位,研究方向,专业要求等详细内容。